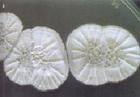
栗色渾圓鏈黴菌

基本信息
栗色渾圓鏈黴菌
栗色渾圓鏈黴菌中文名稱:栗色渾圓鏈黴菌
屬名:Streptomyces
種名加詞:castaneoglobosus
模式菌株:非模式菌株
特徵
孢子絲短,大部牛角狀,少數直。孢子球形或卵圓形,表面光滑。
培養
克氏合成1號瓊脂:氣絲褐灰色,粉狀。基絲深紅褐色。可溶色素深紅褐色。葡糖天冬素瓊脂:氣絲灰色,粉狀。基絲深紅褐色。可溶色素深紅褐色。澱粉瓊脂:氣絲灰色。基絲栗色。可溶色素栗色。馬鈴薯塊:氣絲豐茂,污白色,表層淺灰色。基絲黑褐色。可溶色素黑褐色。瓦氏肉湯瓊脂:無氣絲。基絲淺污黃色。可溶色素芒果棕色。明膠液化強,黑綠色素。牛奶凝固並腖化,深褐色素。澱粉水解弱。纖維素上不生長。硝酸鹽還原。產生類黑色素和H2S。利用D-果糖、甘露醇以及D-甘露糖、檸檬酸鈉;對D-木糖、L-鼠李糖、棉子糖、肌醇以及D-半乳糖、乳糖、麥芽糖、甘油利用可疑;不利用D-阿拉伯糖、蔗糖以及菊糖、衛矛醇、山梨醇、七葉樹素、草酸鈉。對個別革蘭氏陽性細菌(枯草桿菌)和部分絲狀真菌微有作用。
利用
代謝產物具有抗細菌活性
保存方法
-80℃冰櫃凍結法;真空冷凍乾燥法
代表菌株
表菌株:AS4.159,分離自福建土樣。
盤點世界上的微生物(五)
| 微生物是包括細菌、病毒、真菌以及一些小型的原生動物、顯微藻類等在內的一大類生物群體,它個體微小,卻與人類生活關係密切。涵蓋了有益有害的眾多種類,廣泛涉及健康、食品、醫藥、工農業、環保等諸多領域。 |
